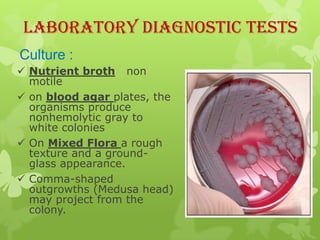
Laboratory Diagnostic Tests
Culture :
 Nutrient broth non
  motile
 on blood agar plates, the
  organisms produce
  nonhemolytic gray to
  white colonies
 On Mixed Flora a rough
  texture and a ground-
  glass appearance.
 Comma-shaped
  outgrowths (Medusa head)
  may project from the
  colony.

1) Anthrax is caused by the bacterium Bacillus anthracis. It can cause serious illness in humans and animals.
2) There are three main types of anthrax disease in humans - cutaneous, inhalation, and gastrointestinal. Cutaneous anthrax is the most common, usually occurring after exposure to infected animals or contaminated products.
3) Anthrax bacteria produce toxins that are major virulence factors. The anthrax toxins are composed of three proteins that combine to cause tissue damage and edema.
4) Diagnosis involves lab tests of samples from lesions, blood, or sputum to identify B. anthracis. Treatment involves antibiotics such as